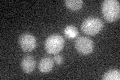
YOR348C
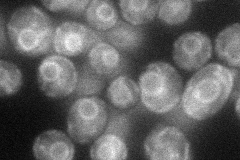
YOR348C
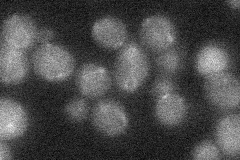
YOR348C

View description
Proline permease, required for high-affinity transport of proline; also transports the toxic proline analog azetidine-2-carboxylate (AzC); PUT4 transcription is repressed in ammonia-grown cells
Localization:
Intensity:
Fold change:
Significance:
-
C’ GFP library in SD
below threshold14.27 -
N' NOP1pr-GFP in SD
ER42.7409 -
N' TEF2pr-mCherry in SD

vacuole47.1131 -
N' NATIVEpr-GFP in SD
below threshold17.1257 -
N' TEF2pr-VC and Cyto-VN in SD

below threshold26.5429 -
C’ GFP library in SD+DTT

cytosol15.821.1No -
C’ GFP library in SD+H2O2

cytosol16.521.15No -
C’ GFP library in Starvation Media

cytosol17.581.23No -
C’ GFP library on the background of Pup2-DaMP

below threshold -
C’ GFP library on the background of CCT mutant

below threshold15.03531.05327No
